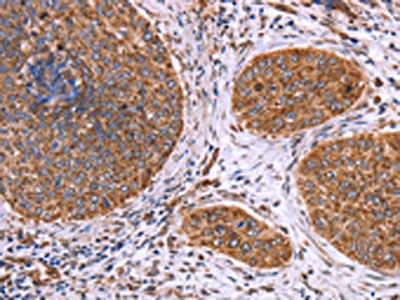

CLUAP1 Antibody
-
中文名稱:CLUAP1兔多克隆抗體
-
貨號:CSB-PA593413
-
規(guī)格:¥1100
-
圖片:
-
The image on the left is immunohistochemistry of paraffin-embedded Human cervical cancer tissue using CSB-PA593413(CLUAP1 Antibody) at dilution 1/50, on the right is treated with fusion protein. (Original magnification: ×200)
-
The image on the left is immunohistochemistry of paraffin-embedded Human tonsil tissue using CSB-PA593413(CLUAP1 Antibody) at dilution 1/50, on the right is treated with fusion protein. (Original magnification: ×200)
-
-
其他:
產(chǎn)品詳情
-
Uniprot No.:
-
基因名:CLUAP1
-
別名:CLUA1_HUMAN antibody; Cluap1 antibody; Clusterin associated protein 1 antibody; Clusterin-associated protein 1 antibody; FLJ13297 antibody; KIAA0643 antibody; Qilin antibody
-
宿主:Rabbit
-
反應(yīng)種屬:Human,Mouse,Rat
-
免疫原:Fusion protein of Human CLUAP1
-
免疫原種屬:Homo sapiens (Human)
-
標(biāo)記方式:Non-conjugated
-
抗體亞型:IgG
-
純化方式:Antigen affinity purification
-
濃度:It differs from different batches. Please contact us to confirm it.
-
保存緩沖液:-20°C, pH7.4 PBS, 0.05% NaN3, 40% Glycerol
-
產(chǎn)品提供形式:Liquid
-
應(yīng)用范圍:ELISA,IHC
-
推薦稀釋比:
Application Recommended Dilution ELISA 1:2000-1:10000 IHC 1:100-1:300 -
Protocols:
-
儲存條件:Upon receipt, store at -20°C or -80°C. Avoid repeated freeze.
-
貨期:Basically, we can dispatch the products out in 1-3 working days after receiving your orders. Delivery time maybe differs from different purchasing way or location, please kindly consult your local distributors for specific delivery time.
-
用途:For Research Use Only. Not for use in diagnostic or therapeutic procedures.
相關(guān)產(chǎn)品
靶點詳情
-
功能:Required for cilia biogenesis. Appears to function within the multiple intraflagellar transport complex B (IFT-B). Key regulator of hedgehog signaling.
-
基因功能參考文獻(xiàn):
- Two variants in CLUAP1 were identified through exome-sequence analysis, Chr16:g.3558407T>G, c.338T>G, p.(Met113Arg) and Chr16:g.3570011C>T, c.688C>T, p.(Arg230Ter). he genetic data show that these variants are present in an affected child, are rare in the population, and result in reduced, but not absent, intraflagellar transport. PMID: 28679688
- Consistent with the knowledge that CLUAP1 plays an important role in cilia function and that cilia are critical to photoreceptor function, our results indicate that hypomorphic mutations in CLUAP1 can result in dysfunctional photoreceptors without systemic abnormalities. This is the first report linking mutations in CLUAP1 to human disease and establishes CLUAP1 as a candidate Leber congenital amaurosis gene PMID: 26820066
- inactivation of CLUAP1 may conceivably serve in the future as a novel therapeutic intervention for treatment of colon cancer PMID: 15480429
- CLUAP1 (clusterin-associated protein 1) is highly expressed in osteosarcoma, ovarian, colon, and lung cancers PMID: 17203229
-
亞細(xì)胞定位:Cell projection, cilium. Nucleus.
-
蛋白家族:CLUAP1 family
-
組織特異性:Expressed in testis, thyroid and trachea and to a lower extent in spinal cord and adrenal gland. Highly expressed in colon cancer and osteosarcoma cell lines.
-
數(shù)據(jù)庫鏈接:
Most popular with customers
-
-
YWHAB Recombinant Monoclonal Antibody
Applications: ELISA, WB, IHC, IF, FC
Species Reactivity: Human, Mouse, Rat
-
Phospho-YAP1 (S127) Recombinant Monoclonal Antibody
Applications: ELISA, WB, IHC
Species Reactivity: Human
-
-
-
-
-